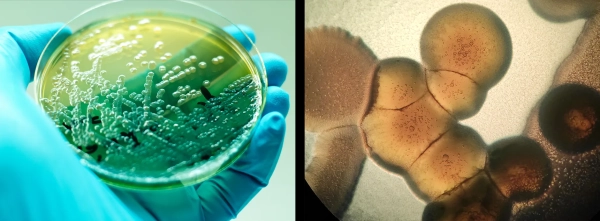
Бактериальный вид Pseudomonas aeruginosa, который образует биопленку в легких пациентов с муковисцидозом, показан двумя способами: слева он выглядит как полосы на чашке Петри, удерживаемой в руке в перчатке; справа он представлен на изображении с микроскопа, показывающем клетки крупным планом.

Поиск простых правил для создания микробного сообщества
Микробиологи ищут универсальную теорию того, как бактерии формируют сообщества, основанные не на их виде, а на ролях, которые они играют. Комментарий Сохранить статью Прочитать позже
Видовое название микроба несет мало информации о его функции. Например, род Streptococcus, один из представителей которого показан здесь, чрезвычайно разнообразен: он включает бактерии, которые живут в здоровом кишечнике, те, которые производят швейцарский сыр, и те, которые вызывают такие заболевания, как стрептококковая ангина и конъюнктивит.
Введение
Бактерии не устраивают званые обеды и не рассказывают анекдоты, но они по-своему социальны. Когда наличие пищи дает им возможность расти, размножаться и развиваться, они быстро, даже охотно, образуют сообщества. Подобно портовому городу, возникшему вдоль водного пути, разнообразное сообщество бактерий и других микробов распознает благоприятную ситуацию для роста и будет самоорганизовываться.
У каждого бактериального города есть история происхождения. Месяцы бродящего вина, биопленка в легких пациента с муковисцидозом и богатый серой горячий источник — все это началось с набора клеток-основателей, которые затем сформировали надежную сеть взаимодействующих видов. Эти сообщества могут выполнять биохимические функции, которые ни один вид не может выполнять сам по себе. Требуется кворум штаммов Lactococcus и Streptococcus, работающих вместе, чтобы придать сыру чеддер его текстуру и привкус. Различные комбинации микробиоты кишечника могут усилить или ослабить эффективность таблетки.
Однако нет очевидных правил, объясняющих, как формируется бактериальное сообщество или почему процветают определенные виды. Большинство биологов, столкнувшись с задачей описания сообщества организмов, каталогизируют список имеющихся видов. Но число видов бактерий настолько велико, продолжительность их жизни настолько коротка, а различия между любыми двумя видами настолько незначительны, что названия видов не обязательно содержат полезную информацию.
Вот почему группа физиков, ставших микробиологами, пытается использовать методы секвенирования генома в массовом масштабе, чтобы раскрыть универсальные правила, которые могут управлять бактериальными сообществами — подход к микробам с использованием больших данных. Вместо того чтобы называть виды по имени, они сосредотачиваются на том, что делают организмы, с целью распознать, какие роли являются существенными в данном сообществе.
«Существует избыточность — например, два вида могут выполнять одну и ту же функцию — и один и тот же вид может выполнять разные функции в зависимости от того, [изменилась] ли окружающая среда», — сказал Отто Кордеро, микробиолог из Массачусетского технологического института. «Таксономия не так информативна, как функция».
В прошлом году в лаборатории Кордеро исследование под руководством микробиолога Матти Гралки выявило набор микробных функций, которые можно было предсказать без информации о виде. Охарактеризовав метаболизм 186 различных штаммов бактерий, собранных в Атлантическом океане, он обнаружил, что может предсказать основные пищевые предпочтения данного микроба, основываясь только на его геноме.

В новом исследовании микробиолог-эколог Матти Гралка обнаружил, что он может предсказать пищевые предпочтения микроба, основываясь исключительно на молекулярном составе его генома.
Эта модель позволяет исследователям обходить последовательности генов, участвующих в расщеплении того или иного источника пищи. Команда Гралки обнаружила, что они могут предсказать предпочтительную пищу, просто измеряя молекулярный состав генома. Результаты были опубликованы в Nature Microbiology.
Пока эта область находится в зачаточном состоянии, микробные экологи ищут способы быстрой оценки и описания естественных микробных сообществ, будь то в дикой среде или в больнице. Разрабатывая теорию микробной сборки, они надеются, что смогут научиться видеть в значительной степени невидимые и быстро меняющиеся микроскопические экологии, разворачивающиеся вокруг нас.
Поле без теории
Микробиология на протяжении столетий была ограничена степенью способности ученых видеть то, что находится перед ними. Даже в начале 2000-х годов, если микробиолог выливал бактериальное сообщество в чашку Петри, это была монументальная задача идентифицировать разнообразные виды, подвиды и штаммы внутри него. Было слишком много организмов, смешанных вместе, приливы и отливы со временем, поскольку доступные источники пищи менялись, а виды жили и умирали. Ученые могли сделать немного больше, чем идентифицировать отдельные колонии по одной за раз по форме, цвету, морфологии и потребностям в питательных веществах.
До недавних пор это оставляло эту область с небольшим количеством определяющей теории для объяснения того, как собираются микробиомы, и без надежных аксиом для интерпретации экспериментальных результатов. В 2007 году группа микробиологов написала в Nature Reviews Microbiology, что это отсутствие теории проистекает как из недостатка данных, так и из общеотраслевой неспособности применять экологическую теорию к микроскопическому миру. Без теории научная область не имеет структуры, формы и предсказательной силы, утверждали они. Микробный эколог может сделать любое наблюдение о сообществе; без теории, объясняющей его важность, все может быть правдой.
«Иногда мы жалуемся, что в микробной экологии нет ничего удивительного», — сказал Альваро Санчес, микробный эколог из Института функциональной биологии и геномики, совместного института Испанского национального исследовательского совета и Университета Саламанки. «У нас нет надежных априорных данных. У нас нет предсказательной теории, поэтому ничто не удивительно».
Однако новые генетические инструменты привели к появлению новых способов описания микробных сообществ. Секвенирование по Сэнгеру, которое на протяжении десятилетий было самым быстрым методом секвенирования генов, позволяло идентифицировать микробы только по одному. Затем, в середине 2000-х годов, появилась технология высокопроизводительного секвенирования, а в 2010-х годах она стала вполне доступной. Микробиологи могли идентифицировать виды по любой ДНК, имеющейся в образце.
Микробные экологи сошли с ума. «Люди секвенировали все до чертиков», — сказал Глен Д'Суза, микробный эколог из Швейцарского федерального технологического института в Цюрихе. «В этой области доминировало описание того, кто там был — этот микроб был в этой среде; этот микроб был в той среде».
Идентификация бактерий, выращенных на пластине (слева) или наблюдаемых под микроскопом (справа), является монументальной задачей. Новые высокопроизводительные геномные инструменты дают ученым значительно улучшенный взгляд на микробные сообщества.
Внезапно избыток данных выявил ранее неизвестное микробное разнообразие. В 2009 году было полностью секвенировано менее 1000 бактериальных геномов. К 2014 году их было более 30 000. С тех пор эта цифра резко возросла: к концу 2023 года насчитывалось 567 228 полных бактериальных геномов, которые легко просматривать и которые можно использовать для перекрестных ссылок. Сегодня на бактерии приходится почти 80% всех доступных геномных данных.
«Люди просто не представляли, сколько видов будет», — сказал Гралка, который теперь руководит собственной лабораторией в Университете VU в Амстердаме. «Их не так уж и хорошо можно отличить под микроскопом».
Однако идентификация отдельных видов бактерий в сообществе может сказать ученым лишь немногое. Их названия не обязательно говорят много о том, какой вклад вносит каждый микроб или как сообщество взаимодействует друг с другом.
«Эти сообщества многомерны», — сказал Якопо Грилли, микробный эколог-теоретик и бывший физик из Международного центра теоретической физики имени Абдуса Салама в Триесте, Италия. «Если мы попытаемся понять [их], нам придется иметь дело с тем фактом, что в этих сообществах существует очень много популяций, много разных видов — что бы ни подразумевалось под словом «вид» — все эти виды имеют свои собственные особенности, и каким-то образом они сосуществуют».
В 2018 году статья Санчеса и его команды в журнале Science дала микробиологам разрешение упростить свое мышление. Их прорывное исследование показало, что если сделать шаг назад и позволить весьма специфическим деталям, таким как точные названия видов, раствориться, можно лучше понять логику бактериального сообщества, как если бы вы рассматривали абстрактную картину с расстояния.
Как и Грилли, Санчес был физиком, прежде чем заняться микробной экологией. «Я решил заняться экологией и микробными сообществами, потому что заметил, что на количественном уровне эта область изучена не так хорошо, как эволюция», — сказал Санчес.
Для исследования его лаборатория выращивала дикие бактерии, культивируемые из мертвых листьев и почвы вокруг Нью-Хейвена, Коннектикут. Они обнаружили, что при одинаковых условиях окружающей среды — одних и тех же источниках углерода, температуре, кислотности и т. д. — любое микробное сообщество придет примерно к одному и тому же функциональному составу, независимо от того, как оно начиналось. В его экспериментах с каждой популяцией появлялись и заполнялись одни и те же ниши снова и снова, хотя не обязательно одними и теми же видами бактерий.
Исследование изменило то, как микробиологи смотрят на сообщество. Когда Санчес сравнивал сообщества, взятые из одной и той же среды, названия бактерий всегда были разными, сказал Д'Суза. «Но если вы посмотрите на функциональное содержание генов, например, кто что делает? Это удивительно похоже», — сказал он. «Так что неважно, кто вы; важно то, что вы делаете».
Предсказательная сила генома
В 2018 году Гралка только что прибыл в Бостон, чтобы работать постдоком в лаборатории Кордеро в Массачусетском технологическом институте. Он начинал как биофизик, изучая физические свойства клеток, по отдельности и в совокупности. Он решил присоединиться к исследовательской программе Кордеро, потому что у двух исследователей были схожие взгляды: разработать количественное, общее понимание микробных сообществ.
У Кордеро был морозильник, заполненный микробами Атлантического океана, которые его лаборатория использовала для того, чтобы сделать интересное открытие о том, как микробные сообщества формируются вокруг источников пищи, опубликованное в Current Biology в 2019 году. Они бросали шарики хитина — полимера повторяющихся молекул сахара, из которого состоят панцири насекомых — в культуры бактерий, выращенных из морских образцов. Когда ученые выловили шарики обратно, они посмотрели, какие сообщества образовались. Микробы, питающиеся хитином, предсказуемо цеплялись за хитин, — но были и бактерии, которые не питались хитином. Эти бактерии, казалось, питались побочными продуктами, выделяемыми поедателями хитина. Поедатели хитина и поедатели побочных продуктов образовали сообщество.

В 2018 году микробный эколог Альваро Санчес обнаружил, что ниши в микробном сообществе предсказуемы при условии одинаковых начальных условий.
Это заинтриговало Гралку. Казалось возможным, что тип сообщества можно предсказать только по его источникам пищи: по изначальному источнику пищи, а затем по новым источникам, созданным, когда первоначальные бактерии его разрушили. Он задался вопросом, сможет ли он предсказать дугу изменений микробного сообщества, если он будет контролировать его начальные условия.
Затем, как раз когда он присоединился к лаборатории Кордеро, «из лаборатории Альваро [Санчеса] вышла статья, которая произвела большой фурор», — сказал Гралка, — работа 2018 года, показывающая, что появляются предсказуемые микробные ниши, которые могут быть заполнены многими различными видами. Идея о том, что функция имеет большее значение, чем вид, показалась ему разумной. «В почве иногда можно найти тысячи различных бактерий. И тогда это очень быстро открывает вопросы», — сказал он. «Как существуют тысячи видов? Конечно, не существует тысяч различных ниш».
Объединив эти два открытия Кордеро и Санчеса, Гралка задался вопросом, сможет ли он не только предсказать микробное сообщество по его исходному источнику пищи, но и вывести ниши по геномам бактерий.
Гралка взял образцы из морозильника Кордеро. Сначала ему нужно было охарактеризовать бактерии на основе предпочитаемой ими пищи. Используя высокопроизводительные инструменты, он вырастил 186 различных видов бактерий в культурах, дополненных 135 различными источниками пищи. В общей сложности Гралка измерил темпы роста более 25 000 образцов бактерий.
В 186 видах бактерий столько же разнообразия, сколько и в 186 разных людях, и, как и у людей, у каждой бактерии есть свои собственные шаблоны и привычки. Некоторые из бактерий Гралки быстро росли на сахарах, а другие быстро росли на кислотах, включая органические кислоты, такие как лимонная кислота, а также аминокислоты, строительные блоки белков. Используя эти данные, Гралка поместил виды на то, что он назвал осью сахар-кислота, на основе их предпочтений.
Затем он секвенировал ДНК всех 186 видов, чтобы увидеть, как они эволюционно связаны. Гралка был удивлен, увидев, что близкородственные виды в пределах одних и тех же филогенетических семейств часто имели разные метаболические предпочтения. Например, отряд палочковидных бактерий Alteromonadales включал в себя пожирателей кислот Colwellia, пожирателей сахара Paraglaciecola и менее разборчивых Pseudoalteromonas, которые питались обоими. Это подтверждало более широкую идею о том, что названия видов не несут большой информации о функции бактерий в данном микробном сообществе.
Затем анализ Гралки углубил ДНК насекомых. Чтобы связать геном с метаболической функцией, он искал гены, которые, как известно, участвуют в переваривании и метаболизме сахаров, и делал то же самое для кислот. Он обнаружил, что количество генов, поедающих сахар или кислоту, предсказывало, где каждый микроб окажется на спектре сахара-кислоты: чем больше генов у вида для того или иного процесса, тем больше вероятность, что он окажется на этом конце оси. Результаты показали, что микробиологи могут приблизительно установить метаболизм сообщества, ища последовательности определенных генов.

Микробные сообщества играют ключевую роль в каждом экологическом цикле на Земле и встречаются практически повсюду — даже в экстремальных местах обитания, таких как богатые серой горячие источники Йеллоустонского национального парка.
Затем он обнаружил нечто более удивительное. Игнорируя фактические последовательности генов, он напрямую посмотрел на молекулярный распад ДНК штамма. В двойной спирали ДНК четыре типа оснований в противоположных цепях спарены, причем гуанин (G) связан с цитозином (C), а тимин (T) связан с аденином (A). Неожиданно, геномы кислотоедов имели в среднем 55% содержания GC, в то время как содержание GC у сахароедов в среднем составляло около 40%. Чтобы подтвердить, что эта корреляция не была причудой его конкретного микробного сообщества, Гралка проанализировал более крупный набор данных из тысяч референтных геномов со всего бактериального древа жизни. Закономерность сохранилась: специалисты по кислотам, как правило, имели более высокое содержание GC, чем специалисты по сахару.
Это правило казалось невообразимо простым. Химия ДНК бактерии предсказывала ее нишу в сообществе. Gralka мог определить, питается ли вид в первую очередь сахарами или кислотами, основываясь только на содержании его генома, вообще не исследуя его гены. Статистика и геномика нашли простой порядок там, где таксономия не увидела никакого.
Прогнозирование микробного будущего
Работа закладывает основу для новой науки о практических прогнозах относительно микробных сообществ. Допустим, трубопровод протекает и разливает сырую нефть в лесу; микробиолог или эколог может захотеть узнать, какие бактерии выскочат, чтобы съесть эту нефть. Врач может захотеть узнать, как микробиом кишечника пациента может измениться в ходе болезни, и потенциально использовать это предсказание для назначения определенных антибиотиков или других лекарств.
На многие вопросы можно ответить и проблемы решить, если исследователи смогут быстро оценить функции микробного сообщества. «В моей лаборатории мы называем это дилеммой тренера», — сказал Санчес. «У вас есть группа игроков, и вы хотите выяснить, кого выпустить на площадку, если хотите максимизировать свой счет. У меня есть список из 100 штаммов; я хочу поместить их в биореактор и получить как можно больше этанола. Так какие штаммы мне следует туда поместить?»
Правила, которые открывают микробные экологи, пока не могут ответить на этот вопрос. Однако быстрая оценка микробного метаболизма — или рабочая теория бактериальных сообществ и их генов — может когда-нибудь быть использована для изучения и управления миром экологических процессов, сказал Гралка.
Микробные сообщества играют ключевую роль в каждом экологическом цикле на Земле. Когда в лесу падает дерево, собирается целая куча грибов и бактерий, чтобы съесть и разложить его, возвращая компоненты дерева в глобальные циклы питательных веществ. С концепциями, введенными Гралкой, Санчесом, Кордеро и другими микробными экологами, ниши этого нового сообщества предсказуемы. Древесина в основном состоит из целлюлозы и гемицеллюлозы, которые являются полимерами глюкозы; следовательно, функционирующее сообщество, созревшее для участия в разложении леса, будет содержать бактерии, питающиеся сахаром, будет иметь большое количество генов, переваривающих сахар, и иметь геномы, состоящие из более низкой доли молекул GC. Внезапный и загадочный всплеск кислотоедов может быть признаком чего-то неладного, предположил Гралка.
Ось сахар-кислота — это только один вид ниши сообщества, которую эти микробные экологи хотят определить. Кордеро предложил лесную экосистему в качестве примера их конечной цели. Экологи определили много общих черт и функций, которые являются общими для лесов и различаются между ними, что позволяет проводить сравнение и прогнозирование.
«Сколько биомассы на листьях по сравнению со стволом? [Оказывается], растения с большими листьями дышат больше в тропических условиях», — сказал Кордеро. «Насколько глубоки корни? Это говорит о том, сколько питательных веществ они могут взять из окружающей среды. Как быстро они будут расти? Насколько они высокие? Насколько хорошо они [конкурируют] за свет?» Знание даже нескольких из этих переменных может многое рассказать нам о динамике леса.
Кордеро не знает, какие аналогичные черты могут быть у микроорганизмов и их сообществ. Многие бактериальные ниши, несомненно, связаны с их метаболизмом и побочными продуктами, но есть и другие аспекты, которые следует учитывать. «Если бы у нас были способы узнать, что это за переменные… и способы их систематической идентификации, это было бы потрясающе», — сказал он.
В каком-то смысле эти ученые впервые экологически картируют микробные сообщества. Их работа предлагает новый взгляд на то, что на самом деле представляет собой микробное сообщество, — показывая, что то, чем являются микробы, лучше всего определяется тем, что они делают.
Примечание редактора: Кордеро возглавляет Simons Collaboration on Principles of Microbial Ecosystems, исследовательскую программу, поддерживаемую Simons Foundation, которая также финансирует этот редакционно независимый журнал. Решения о финансировании Simons Foundation не влияют на наше освещение.
Источник: www.quantamagazine.org
